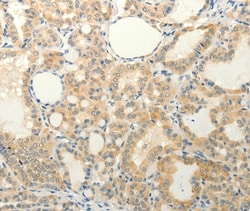

missing translation for 'onlineSavingsMsg'
Learn More
Learn More
Invitrogen™ FAT3 Polyclonal Antibody
Rabbit Polyclonal Antibody
Marca: Invitrogen™ PA550588
Este artículo no se puede devolver.
Vea la política de devoluciones
Descripción
The antibody detects endogenous levels of total FAT3 protein.
FAT1, FAT2, FAT3 and FAT4 are human homologs of Drosophila Fat, which is involved in tumor suppression and planar cell polarity (PCP). The atypical cadherin Fat3 ensures that retinal amacrine cells (ACs) develop this unipolar morphology. Fat3 expression was restricted to the nervous system, for example in the brain, it is expressed in a variety of regions and axon fascicles. However, its strongest expression was observed in the olfactory bulb and retina.
Especificaciones
| FAT3 | |
| Polyclonal | |
| Unconjugated | |
| FAT3 | |
| 9430076A06Rik; Cadherin family member 15; cadherin-related family member 10; CDHF15; CDHR10; D430038H04Rik; FAT atypical cadherin 3; FAT tumor suppressor homolog 3; FAT tumor suppressor homolog 3 (Drosophila); Fat3; Fta3 protein; Gm1132; Gm510; hFat3; KIAA1989; MFAT3F; protocadherin Fat 3; protocadherin Fat3 | |
| Rabbit | |
| Antigen affinity chromatography | |
| RUO | |
| 120114 | |
| -20°C | |
| Liquid |
| Immunohistochemistry (Paraffin) | |
| 0.7 mg/mL | |
| PBS with 40% glycerol and 0.05% sodium azide; pH 7.4 | |
| Q8TDW7 | |
| FAT3 | |
| Synthetic peptide corresponding to a region derived from internal residues of human FAT tumor suppressor homolog 3 (Drosophila). | |
| 100 μL | |
| Primary | |
| Human | |
| Antibody | |
| IgG |
Corrección del contenido de un producto
Proporcione sus comentarios sobre el contenido del producto rellenando el siguiente formulario.
Título del producto
Spot an opportunity for improvement?Share a Content Correction